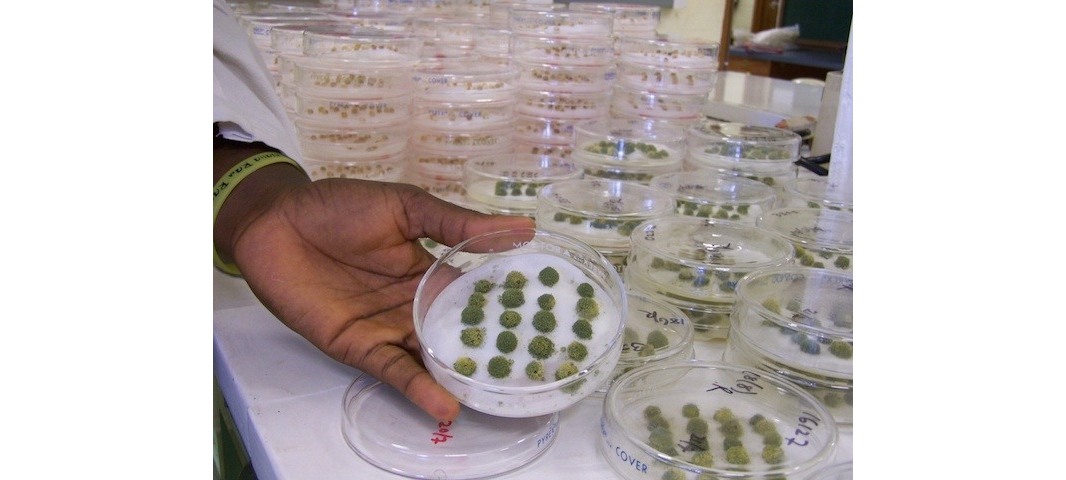

Aposta em bioproduto contra aflatoxinas
Por Ini Ekott, da IPS – Abuja, Nigéria, 9/1/2017 – Entre as substâncias que contaminam os alimentos, as aflatoxinas estão entre as mais letais. Entre 2004 e 2007, milho contaminado deixou quase 200 mortos no Quênia, centenas de pessoas hospitalizadas e foram jogados no lixo milhões de sacas.
Por Ini Ekott, da IPS –
Abuja, Nigéria, 9/1/2017 – Entre as substâncias que contaminam os alimentos, as aflatoxinas estão entre as mais letais. Entre 2004 e 2007, milho contaminado deixou quase 200 mortos no Quênia, centenas de pessoas hospitalizadas e foram jogados no lixo milhões de sacas. Aproximadamente, entre 25% e 60% do milho, um produto básico em muitos países africanos, contém alto grau de aflatoxinas na Nigéria, alertou o Instituto Internacional de Agricultura Tropical (IITA).

Agricultores aplicam Aflasafe em cultivos de amendoim. Foto: Cortesia da Aflasafe.com
Essa toxina eleva o risco de câncer de fígado, debilita o sistema imunológico, atrasa o crescimento de meninos e meninas, e pode causar a morte, sendo extremamente perigosa. Mas agora o Aflasafe, um produto de biocontrole fabricado na África, combate sua toxidade e leva esperanças para milhões de pessoas que dependem de cultivos vulneráveis como o milho.
“As aflatoxinas estão entre as substâncias mais cancerígenas. Mas, nos quatro anos que estamos trabalhando com agricultores, obtivemos grandes resultados com o Aflasafe”, afirmou Adebowale Akande, encarregado do projeto do IITA que desenvolveu o bioprotudo. Um período de teste de quatro anos com essa substância na Nigéria apresentou impressionante redução de aflatoxinas, de 80% a 90%. “Concorda que quatro anos são suficientes para saber se algo funciona ou não?”, perguntou.
A contaminação com aflatoxinas é um problema mundial. Os países ricos analisam os cultivos e destroem os alimentos que superam o limite regular, mas a falta de controle e a pouca consciência existente nas nações em desenvolvimento deixam milhares de milhões de pessoas vulneráveis a esse composto tóxico. O Centro para o Controle de Enfermidades, com sede nos Estados Unidos, estima que 4,5 bilhões de pessoas nos países em desenvolvimento podem estar expostas de forma crônica às aflatoxinas.
Essas toxinas contaminam os produtos básicos da dieta africana, como milho, amendoim e arroz, seja na terra ou na estocagem. Os países em latitudes entre 40 graus Norte e 40 graus Sul, que inclui todo o continente africano, são suscetíveis a essa contaminação, segundo a Partnesrship for Aflatoxin Control in Africa (Paca – Associação para o Controle das Aflatoxinas na África), órgão da União Africana (UA).
“O impacto econômico direto da contaminação por aflatoxinas nos cultivos se deve principalmente à redução da produção apta para comercialização, à perda de valor dos mercados nacionais, à inadmissibilidade ou rejeição de produtos no mercado internacional e ao prejuízo pela perda de gado e à consequente morbidade e mortalidade”, afirma um documento elaborado pela Paca em 2015.
O Aflasafe evita o desenvolvimento do Aspergillus , o gênero de fungo que produz as aflatoxinas, ao estimular o crescimento de grandes quantidades de uma espécie não daninha. Desenvolvido durante uma década graças à colaboração entre IITA, Serviço de Pesquisa Agrícola do Departamento de Agricultura dos Estados Unidos, Universidade de Bonn e Universidade de Ibadán, da Nigéria, o bioproduto é aplicado no solo com as mãos, duas e três semanas antes da floração do cultivo.
Em dois ou três dias após a aplicação, a cepa antitoxigênica do fungo se desenvolve rapidamente, coloniza a plantação e impede o desenvolvimento da cepa tóxica. Assim pode-se eliminar mais de 90% das aflatoxinas. No momento, funciona apenas para o milho e o amendoim, e continuam as pesquisas para aplicá-lo em outros cultivos.
Ainda restam desafios a vencer. A falta de consciência sobre os perigos da aflatoxina faz com que não se exija produtos livres de toxidade. Além disso, a má regulamentação restringe os investimentos para controlá-las. O IITA criou o mecanismo de inserção para expandir o uso de Aflasafe, mediante incentivos econômicos e técnicos para pequenos agricultores, que trabalham em grupos por meio de intermediários, chamados implementadores.
O mecanismo inclui pagamentos por unidade em função da quantidade de quilos de milho tratados com o produto. Os pagamentos premium , que equivalem a US$ 18,75, são feitos para cada tonelada de milho com um grande conteúdo de Aflasafe entregue em pontos de coleta designados. Isso corresponde a uma taxa premium de 5% a 13%, dependendo do preço atual do milho.
O mecanismo de inserção começou em 2012, na Nigéria, com quatro implementadores e mil agricultores. Em 2016, o número aumentou para 25 implementadores e 15 mil agricultores, contou Akande. Em Abaji, um dos bairros de Abuja, um dos beneficiários é Abubakar Yambab, um agricultor de 43 anos, tem 1,5 hectare cultivado com milho. A primeira vez que usou Aflasafe foi em 2015, e sua produção melhorou em quantidade e qualidade, explicou à IPS.
“Elimina as partículas de cores (aflatoxinas) que notávamos no milho colhido e não creio que agora possa cultivar milho sem Aflasafe”, destacou Yambab, acrescentando que recebe fertilizantes subsidiados, equipamentos, tratores e produtos químicos do IITA. Também contou que, graças ao seu trabalho, pode alimentar seus seis filhos e suas duas esposas, além de terminar a construção de um depósito de material.
Receber pagamento premium pelo milho com conteúdo reduzido de aflatoxinas traz benefícios aos agricultores, apesar do investimento na tecnologia do Aflasafe. O IITA informou que, no primeiro ano de testes, os agricultores tiveram um preço de venda 13% acima do exercido no mercado, uma rentabilidade de 210%. Em 2015, o preço de venda médio foi 15% acima, ou seja, rentabilidade de 524%.
A Nigéria foi eleita como local de provas para o Aflasafe por ser o maior produtor e consumidor de amendoim na África subsaariana, e porque até 60% de seu cultivo estavam contaminados. Agora, esse país é o único em desenvolvimento onde o Aflasafe está pronto para ser usado pelos produtores. Há uma fábrica que produz cinco toneladas do produto por hora, na sede do IITA, na cidade nigeriana de Ibadán, e está sendo construída uma no Quênia e outra no Senegal.
O Instituto também trabalha na transferência de tecnologia para que as empresas possam produzir e distribuir Aflasafe para milhões de agricultores na África subsaariana. “Está previsto cobrir cerca de 500 mil hectares em 11 países, onde logo o Aflasafe será registrado”, detalhou Matieyedou Konlambigue, responsável pelo Projeto de Comercialização e Transferência da Tecnologia Aflasafe, na apresentação da iniciativa, no dia 1º deste mês, em Ibadán.
Os países previstos são Burkina Faso, Gana, Quênia, Malawi, Moçambique, Nigéria, Senegal, Tanzânia, Gâmbia, Uganda e Zâmbia, disse Konlambigue, segundo a Agência de Notícias da Nigéria. O projeto, iniciado em 2016, se estenderá até 2020. Yambab ressaltou que recomendará o Aflasafe a outros produtores. “Se todos os do território da capital federal o usarem, realmente vai melhorar a qualidade dos produtos alimentares da região”, afirmou. Envolverde/IPS




